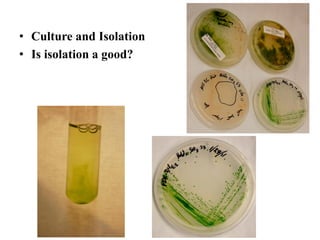
• Culture and Isolation
• Is isolation a good?

Microalgae are a diverse group of photosynthetic organisms that can be used to produce biodiesel. They contain lipids and oils that can be extracted and processed into biodiesel. Microalgae have several advantages over terrestrial crops for biodiesel production as they have a higher oil yield per acre, can be grown on non-arable land or wastewater, and are more sustainable as they are carbon neutral. The production of biodiesel from microalgae involves cultivating the algae, harvesting it, extracting the oil, and processing the oil through transesterification to produce the biodiesel. As the technology advances, algae-derived biodiesel production is increasing with over 100 companies now